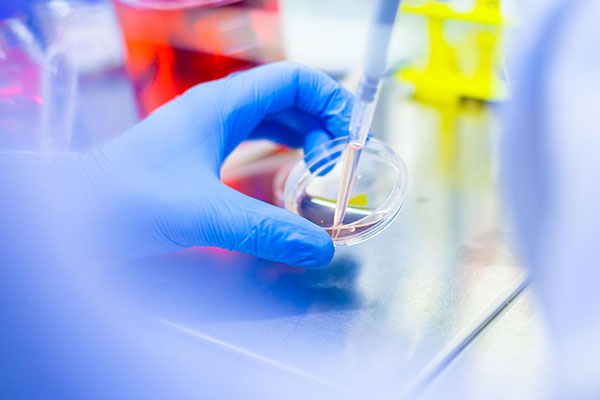
Ręka w niebieskiej rękawiczce trzyma szalkę Petriego, do której wkładana jest pipeta z płynem. W tle rozmyte elementy laboratorium: czerwony pojemnik z cieczą i żółty stojak na probówki. Scena przedstawia pracę badawczą w laboratorium.

Fokus na WUM - 2025

W programie wydarzenia, które odbyło się 7 czerwca w murach naszej uczelni, znalazły się wykłady klinicznych logopedów i specjalistów w dziedzinie neurologopedii, reprezentujących różne ośrodki medyczne i uczelnie z całej Polski. Konferencja zgromadziła ponad 350 uczestników z całego kraju, nie tylko logopedów, ale i lekarzy, co świadczy o rosnącym znaczeniu interdyscyplinarnego podejścia do terapii pacjentów z zaburzeniami komunikacji i funkcji połykania.

Przedstawiciele WUM oraz reprezentanci Fundacji Omenaa Foundation spotkali się w murach uczelni, aby porozmawiać o przygotowaniach do wolontariackiego wyjazdu studentów WUM do Ghany.

Nasza uczelnia bierze udział w międzynarodowym projekcie ERUDiTE. Jego celem jest wzmacnianie empatii wśród studentów i pracowników zawodów medycznych oraz tworzenie bardziej wspierającego i humanistycznego środowiska edukacyjnego w ramach empatycznej organizacji. W ramach projektu zostaną stworzone narzędzia dydaktyczne wspierające rozwój rozwój empatii oraz propozycje działań na poziomie instytucjonalnym służące promowaniu empatii w edukacji i organizacji.

Studenci działający w kole wzięli udział w pikniku „Odważ się być zdrowym”, organizowanym przez Fundację Instytutu Matki i Dziecka. I zadbali o to, by wszyscy uczestnicy – mali i duzi - mogli dowiedzieć się czegoś ciekawego o swoim zdrowiu.

Czy można przewidzieć, które blaszki miażdżycowe spowodują zawał, zanim pacjent w ogóle poczuje ból w klatce piersiowej? Jeszcze kilkanaście lat temu pytanie to brzmiałoby jak medyczna fantastyka, dziś jednak indywidualizowane działania prewencyjne stają się codziennością. A to dzięki postępom w ocenie zwężeń tętnic wieńcowych i coraz śmielszemu stosowaniu sztucznej inteligencji oraz innych komputerowych metod przez specjalistów kardiologów – pisze Adrian Bednarek, student kierunku lekarskiego, doktorant w I Katedrze i Klinice Kardiologii WUM.

To były pierwsze takie zajęcia zorganizowane dla studentów II roku ratownictwa medycznego w ramach przedmiotu medycyna taktyczna. Po co? Bo w przyszłości mogą stanąć przed koniecznością prowadzenia działań ratunkowych w terenie, w wymagających i niesprzyjających okolicznościach, w tym warunkach bojowych.

Pięcioro specjalistów z WUM znalazło się w gronie najlepszych naukowców świata w 4. edycji rankingów Research.com. Rankingi zostały przygotowane w oparciu o różnorodne źródła bibliometryczne, a analiza objęła ponad 166 tys. przedstawicieli nauki.

Podczas wydarzenia poznaliśmy zaskakujące wyniki najnowszego raportu dotyczącego miejsca Polski na światowym rynku badań klinicznych. Eksperci rozmawiali również o wykorzystaniu sztucznej inteligencji, innowacyjnych terapiach oraz organizacji centrów wsparcia badań klinicznych.
Dzięki dofinansowaniu od Narodowego Centrum Nauki w ramach konkursu SONATA 20 i OPUS 28 badaczki i badacze z naszej uczelni zrealizują innowacyjne projekty. Wszystkie dotyczą ważnych obszarów współczesnej medycyny.

Z mistrzostw przywieźli 13 medali i brązowy puchar, bo męska reprezentacja zajęła 3. miejsce na podium w klasyfikacji uczelni medycznych!